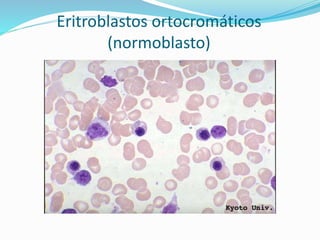
Eritroblastos ortocromáticos
(normoblasto)

El documento describe el proceso de hematopoyesis, que es el mecanismo fisiológico responsable de la formación continua de los diferentes tipos de elementos sanguíneos a través de la proliferación y diferenciación de células precursoras. Se detalla que la hematopoyesis ocurre principalmente en la médula ósea a través de los procesos de eritropoyesis, granulopoyesis y megacariopoyesis, los cuales generan eritrocitos, granulocitos y plaquetas respectivamente, a partir de células madre y progenitores